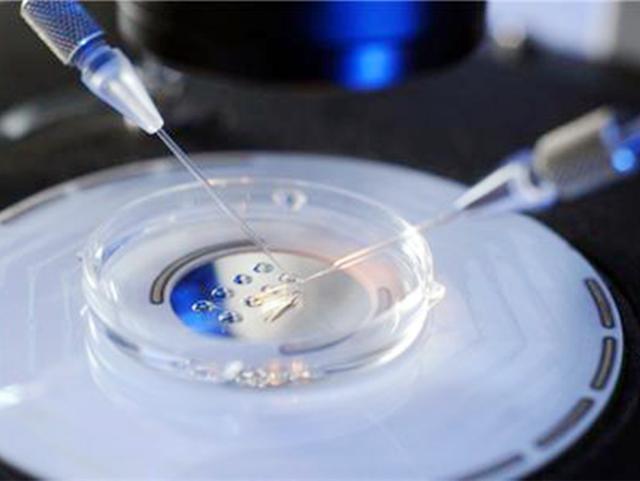
试管婴儿到底有多疼,做试管婴儿看得心疼

本文为木莲妈妈原创作品,图片为木莲妈妈原创插画,欢迎个人评论分享收藏。
诞下一个新生命,可能是大多数夫妻之间共同的愿望,这代表着是下一代的血缘延续,也寄托了亲人们的期望。

可是并不是每一对夫妇都能很容易的如愿孕下后代,比如一些患有不孕和不生育病症的女性,或是丈夫身体出现问题,可能就不得不借助其他的手段来诞下新生命。
这时很多人想到的方法,就是进行“试管婴儿”,可“试管婴儿”说起来容易,女性那一方经受的痛苦却不是常人所能想象和理解的。
这几张图片为大家展示“试管婴儿”的全过程,看完就会明白,作为妈妈,是多么伟大辛苦又令人感动的事。
试管婴儿到底有多疼?这几张图为您“*放播**”全过程,让人心疼。

1、事前要做身体检查
进行“试管婴儿”,夫妻双方的年纪其实是有限定的,通常情况下,妻子的年纪最好别超过四十岁,丈夫的年龄最好不超过四十五岁。
然后夫妻双方需要做身体的检查,确定身体条件符合“试管婴儿”的要求。
2、监测卵子
在一周或是两周的时间内,医生需要控制排卵状况,之后就用B超或是彩超时刻监视卵泡的状态,以供合适时机取卵。

3、排卵期及时取卵及取精
妻子那一方要进行排卵的预测,之后要做取卵,这个过程是十分痛苦的,是用长针刺入女方的*处私**取卵,痛苦的程度是常人难以忍受的。
男方则是取精,这个过程相较于妻子那一方来说,是比较轻松的,而且取卵和取精子是要同时完成的。
4、精子和卵子体外培养
从夫妇双方身体里取出来的精子和卵子,会及时的放在培养皿里培养十八个小时,根据在里面的详细受精情况,若是效果不好,就需要重新取卵,如此反复之下,对于妻子的那一方是很煎熬和痛苦的。
5、受精卵移植体内孕育
在培养皿里培育两到三天,根据实际情况,医生会判断放置多少胚胎进母体比较适宜,这也是“试管婴儿”有时会诞生双胞胎的原因。

6、注射激素帮助孕产
当胚胎移植到母体以后,还需要定时的给母体注射一些激素帮助胎儿发育孕产,为了新生命的更好生长。
7、检验身体受孕情况
移植胚胎以后,妈妈们还需要在两周后,定时去抽血验血,或者检验尿液,确定受孕的情况,若是成功受孕便是皆大欢喜,若是不幸失败,就只能从头开始所有的准备,这也是最考验妈妈们心理承受力的时候。

8、一个月B超检查
当一个月之后,就可以正常通过B超检查胎儿的状况了,之后就和其他的自然受孕的妈妈们一样,直到生产诞下新生命,“试管婴儿”就完成了。
若是试管婴儿成功以后,妈妈们还需要注意的一些是:
1、忌口是必要的
受孕以后,妈妈们是不能吃一些重口味的东西,要以清清淡淡的饭菜为主,果蔬也是不能少的,必须要摄入足量的维生素才行。

2、心情影响受孕情况
一些做试管婴儿的女性,最担心的事情就是中途流产,这意味着之前的所有努力和忍受的痛楚就要重新来过了,难免伴随着一些焦虑的心情。
这就要求妈妈们保持心情的舒畅,避免过于紧张和恐慌。
知道了试管婴儿的全过程,作为丈夫,应该更加的疼爱自己的另一半,妈妈们所受的苦是难以想象的,因此日常生活中要多照顾另一半,共同迎接新生命的到来。
我是木莲妈妈,是一名高级育婴师兼插画师,也是4岁孩子的妈妈。如果您在育儿路上,有关于孩子心理、饮食以及日常护理等方面的问题和困扰,可以来找我。